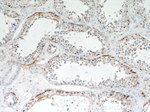
PYCR2 Antibody in Immunohistochemistry (Paraffin) (IHC (P))

Search
Proteintech
PYCR2 Polyclonal Antibody
{{$productOrderCtrl.translations['antibody.pdp.commerceCard.promotion.promotions']}}
{{$productOrderCtrl.translations['antibody.pdp.commerceCard.promotion.viewpromo']}}
{{$productOrderCtrl.translations['antibody.pdp.commerceCard.promotion.promocode']}}: {{promo.promoCode}} {{promo.promoTitle}} {{promo.promoDescription}}. {{$productOrderCtrl.translations['antibody.pdp.commerceCard.promotion.learnmore']}}
产品信息
17146-1-AP
种属反应
已发表种属
宿主/亚型
分类
类型
抗原
偶联物
形式
浓度
规格
纯化类型
保存液
内含物
保存条件
运输条件
产品详细信息
Immunogen sequence: MSVGFIGAG QLAYALARGF TAAGILSAHK IIASSPEMNL PTVSALRKMG VNLTRSNKET VKHSDVLFLA VKPHIIPFIL DEIGADVQAR HIVVSCAAGV TISSVEKKLM AFQPAPKVIR CMTNTPVVVQ EGATVYATGT HALVEDGQLL EQLMSSVGFC TEVEEDLIDA VTGLSGSGPA YAFMALDALA DGGVKMGLPR RLAIQLGAQA LLGAAKMLLD SEQHPCQLKD NVCSPGGATI HALHFLESGG FRSLLINAVE ASCIRTRELQ SMADQEKISP AALKKTLLDR VKLESPTVST LTPSSPGKLL TRSLALGGKK D (1-320 aa encoded by BC020553)
靶标信息
PYCR2 belongs to the pyrroline-5-carboxylate reductase family. The function of the PYCR2 protein is not known.
仅用于科研。不用于诊断过程。未经明确授权不得转售。
生物信息学
蛋白别名: P5C reductase 2; P5CR 2; PCR-2; Pyrroline-5-carboxylate reductase 2; pyrroline-5-carboxylate reductase family member 2; unnamed protein product
基因别名: 1810018M05Rik; HLD10; P5CR2; PYCR2
UniProt ID: (Human) Q96C36, (Mouse) Q922Q4, (Rat) Q6AY23
Entrez Gene ID: (Human) 29920, (Mouse) 69051, (Rat) 364064